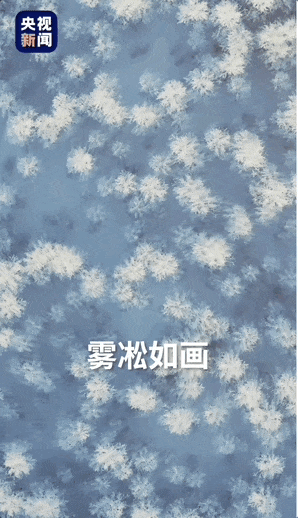

编辑:林媛媛2023-12-15 09:30内容来源:央视新闻微信公众号
这里是吉林长春
最早的名字叫“茶啊冲”

有雾凇如画的北国风光
有绵绵黑土和皑皑白雪

这里有热烈、蓬勃、乐观的文化
和辛勤耕耘的人们
来长春,邂逅一个极致的冬天❄️
01
无数个“第一”在这里诞生
数发展“长春”,还看今朝
近几十年来
中国第一辆轨道客车
中国第一台激光器
中国第一台电子显微镜
无数个“第一”在这里诞生
黑土地上,良田千里
湖泊之中,鱼虾肥美
地面之下,油气丰富

达观的市民
古朴与现代并存的城市
冰天雪地的独特景观
热气腾腾的生活
在寒暖之间流动着
“长春”青春力
02
“东北孩子的快乐谁懂啊!”
在长春
有种专属艺术叫“冰雪新天地”
2023—2024第五届长春冰雪节
12月12日正式跟大家见面
拥有67万平方米的冰雪游乐空间
30余项冰雪娱乐项目
总台主持人李梓萌和冬奥冠军周洋
玩出了“滑”样年华

如何优雅地拍出雪景大片?
冰糖葫芦是如何被东北人“玩明白”的?
在东北,除了铁栏杆啥都好吃?

冰天雪地也是宝藏
长春靠独特的自然禀赋
“玩”出热门产业
还是吉林省
高质量发展的一个全新注释
冰雪运动、冰雪产业、冰雪装备等
正在这里热“雪”沸腾,焕发生机
除了惊艳的“雪道”
还有优质的产业“赛道”
除了来看看雪
也能来瞅瞅雪中的机遇

03
《五朵金花》《上甘岭》《英雄儿女》等
影响中国几代人的优秀影片
在这里诞生
长影标注了新中国电影梦开始的地方
也在继续为年青一代不断创造经典记忆
今天,年轻人们又来到这里
跟着《人世间》《父辈的荣耀》打卡
创作出一幕幕新鲜有趣的文化新业态

04
制造业是长春硬核的名片
地上跑的、天上飞的都遥遥领先
长春是中国汽车城
也是我国核心的
轨道客车研发、制造和出口基地
研制出中国第一列地铁
第一列动车组
我国完全知识产权的
“复兴号”从这里驶出
为中国各个城市带来快捷交通
“中国速度”也从“茶啊冲”冲向世界
“茶啊冲”的冲速
正随着东北全面振兴继续上扬
中国第一颗商用遥感卫星
来自长春的长光卫星
一箭41星刷新了
我国一次发射卫星数量最多的纪录
目前天上飞的“吉林一号”
共有108颗卫星在轨运行
作为行走在太空的摄像机
它们在农林生产、环境监测
土地规划、地理测绘等领域
发挥着重要作用

广袤大地上
长春制造的高铁动车飞速奔驰
无垠宇宙中
“吉林一号”探索星辰大海
05
在长春,有一句玩笑话
“美丽的长春市坐落在吉林大学里”
吉林大学校区多、面积大
这也是长春高校密度的一个缩影
坐拥49所高校
是城市发展的底气、动力
在冰上秀绝活
这是只有在东北才能体会到的极致快乐

冰上项目不含糊,学习科研界更厉害
在光学电子、精密仪器
生物工程和汽车技术等高精尖领域
莘莘学子各自攀登,努力顶峰相见
他们是长春发展的中坚力量
也是建设东北的未来砥柱
这份初生牛犊的“青年力”
“青”爱的城持续向前的发展力
从“茶啊冲”,到“喜都”,再到长春
几千年来
长春的过去被历史、地理和文化塑造
长春的今日
则由时代、发展和青年共同创造
相关新闻